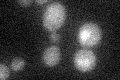
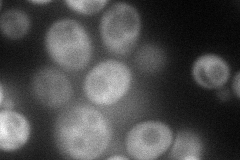
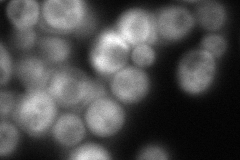
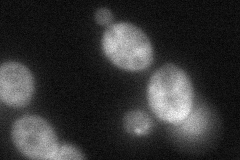
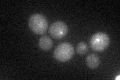

View description
Protein involved in G2/M phase progression and response to DNA damage, interacts with Rad53p; contains an RNA recognition motif, a nuclear localization signal, and several SQ/TQ cluster domains; hyperphosphorylated in response to DNA damage
Localization:
Intensity:
Fold change:
Significance:
-
C’ GFP library in SD
below threshold15.68 -
N' NOP1pr-GFP in SD
cytosol91.7577 -
N' TEF2pr-mCherry in SD
cytosol104.954 -
N' NATIVEpr-GFP in SD

cytosol59.3679 -
N' TEF2pr-VC and Cyto-VN in SD
cytosol59.4922 -
C’ GFP library in SD+DTT
cytosol17.281.1No -
C’ GFP library in SD+H2O2

cytosol18.161.15No -
C’ GFP library in Starvation Media

cytosol15.190.96No -
C’ GFP library on the background of Pup2-DaMP

N/A -
C’ GFP library on the background of CCT mutant

N/A0N/AYes
